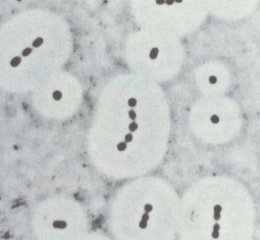

各地 动态 |
全国 | 北京 | 天津 | 上海 | 重庆 | 河北 | 山西 | 贵州 | 黑龙江 | 辽宁 | 吉林 | 江苏 | 浙江 | 安徽 | 福建 | 江西 |
| 河南 | 山东 | 湖南 | 湖北 | 广东 | 海南 | 四川 | 云南 | 内蒙古 | 广西 | 陕西 | 甘肃 | 宁夏 | 青海 | 西藏 | 新疆 |
 微生物学基础知识复习:皮肤、耳、眼部的正常菌群
日期:2012-06-19 11:58:27
点击:226
好评:1
微生物学基础知识复习:皮肤、耳、眼部的正常菌群
日期:2012-06-19 11:58:27
点击:226
好评:1
皮肤、耳、眼部的正常菌群 皮肤表面普遍存在表皮葡萄球菌(Staphylococcus epidermidis),有时有金黄色葡萄球菌(Staphylococcus aureus)。葡萄球菌在脸部与手部皮肤较多见。鼻翼、腋窝及腹股沟等处皮肤较潮湿,还可有大肠埃希菌(Escherichia coli)等革...
 微生物学基础知识复习:人体正常菌群的数量
日期:2012-06-19 11:57:55
点击:193
好评:1
微生物学基础知识复习:人体正常菌群的数量
日期:2012-06-19 11:57:55
点击:193
好评:1
人体正常菌群的数量...
 微生物学基础知识复习:泌尿生殖道中的正常菌群
日期:2012-06-19 11:57:30
点击:114
好评:3
微生物学基础知识复习:泌尿生殖道中的正常菌群
日期:2012-06-19 11:57:30
点击:114
好评:3
泌尿生殖道中的正常菌群 外生殖器的正常菌群较多,常有表皮葡萄球菌、甲型链球菌、肠球菌(Enterococcus)、棒状杆菌、类杆菌、奈瑟氏菌、不动杆菌(Acinetobacter)、耻垢分枝杆菌、支原体(Mycoplasma)、假丝酵母等。这些菌群也可以在男女两性的尿道口发...
微生物学基础知识复习:鼻腔与呼吸道中的正常菌群
日期:2012-06-19 11:55:56
点击:256
好评:1
微生物学基础知识复习:鼻腔与呼吸道中的正常菌群
日期:2012-06-19 11:55:56
点击:256
好评:1
鼻腔与呼吸道中的正常菌群 鼻腔粘膜常有表皮葡萄球菌和金黄色葡萄球菌存在,有时有甲型链球菌、棒状杆菌(Corynebacterium)、布兰汉菌(Branhamella)等。医务人员的鼻腔若带有金黄色葡萄球菌,常会污染病房空气,这就使免疫力低下的病人意外受到感染,我们...
 微生物学基础知识复习:消化道中的正常菌群
日期:2012-06-19 11:54:50
点击:208
好评:1
微生物学基础知识复习:消化道中的正常菌群
日期:2012-06-19 11:54:50
点击:208
好评:1
消化道中的正常菌群 消化道中的正常菌群的种类和数量,在不同部位是不同的。胃酸的酸度很高(pH2-3),因而胃内基本无活菌。空肠和回肠上部的菌群很少。结肠和直肠则有大量细菌,主要是类杆菌(Bacteroides)、双歧杆菌(Bifidobacterium)、大肠埃希氏菌、...
 微生物学基础知识复习:口腔中的正常菌群
日期:2012-06-19 11:52:58
点击:240
好评:0
微生物学基础知识复习:口腔中的正常菌群
日期:2012-06-19 11:52:58
点击:240
好评:0
口腔中的正常菌群 口腔中有弱碱性唾液、食物残渣等,为正常菌群的繁衍提供了合适条件。最常见的菌群是甲型链球菌和厌氧链球菌,其次是表皮葡萄球菌、奈瑟氏菌(Neisseria)、乳杆菌(Lactobacillus)、螺旋体(Spirochaeta)、假丝酵母(Candida)等。当拔牙...
 微生物学基础知识复习:无核与多核细胞简述
日期:2012-05-25 10:42:54
点击:88
好评:7
微生物学基础知识复习:无核与多核细胞简述
日期:2012-05-25 10:42:54
点击:88
好评:7
无核与多核细胞 人类红血球细胞与其他哺乳类一样缺少了细胞核,对这类细胞而言属于正常发育结果。虽然多数细胞都有一个细胞核,但也有些细胞没有细胞核,还有一些则是拥有多个细胞核。这可能属于正常现象,如哺乳类的红血球;也可能是肇因于细胞分裂过程中的...
 微生物学基础知识复习:镰刀菌
日期:2012-05-25 10:42:33
点击:207
好评:0
微生物学基础知识复习:镰刀菌
日期:2012-05-25 10:42:33
点击:207
好评:0
镰刀菌(Fusarium)分布广,种类多,是污染粮食和饲料的常见霉菌菌属之一。 【临床意义】 本菌可产生镰刀菌毒素。食用霉变的粮食可导致人患病和死亡。某些菌种可诱发人皮肤和角膜溃疡。恶性肿瘤的发生可能与有的菌种有关。...
 微生物学基础知识复习:细胞骨架简述
日期:2012-05-25 10:42:10
点击:127
好评:1
微生物学基础知识复习:细胞骨架简述
日期:2012-05-25 10:42:10
点击:127
好评:1
动物细胞内有两种用来支撑细胞核的中间纤维:其中核纤层为一种有系统的网状结构,分布于核模内侧;而另一种较缺乏系统的支撑构造则位于核模外侧。两种结构除了支撑核模外,也是染色体与核孔的赖以固定的位点。 核纤层主要是由层蛋白所构成,与多数蛋白质相同...
 微生物学基础知识复习:细菌简述
日期:2012-05-25 10:41:31
点击:135
好评:0
微生物学基础知识复习:细菌简述
日期:2012-05-25 10:41:31
点击:135
好评:0
细菌(英文名:Bacteria)是生物的主要类群之一,属于细菌域。细菌是所有生物中数量最多的一类,据估计,其总数约有 51030个[1].细菌的个体非常小,目前已知最小的细菌只有0.2微米长[2] ,因此大多只能在显微镜下看到它们。细菌一般是单细胞,细胞结构简单,...